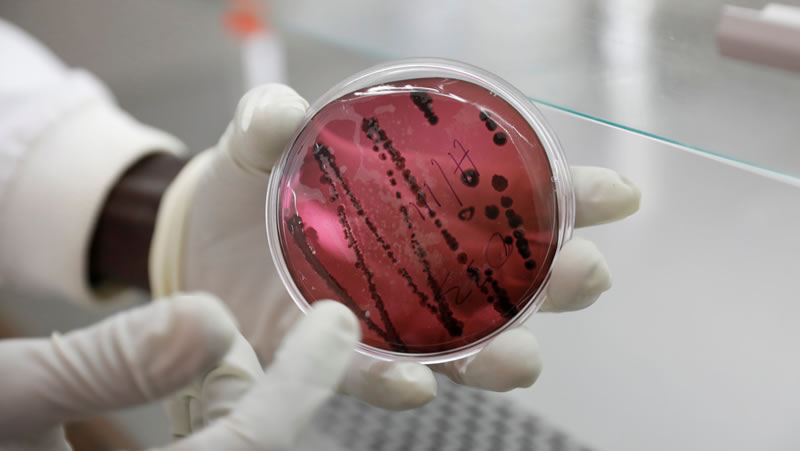

En 2019 se registraron cinco infecciones del arenavirus Chapare, entre las cuales hubo tres fallecimientos.
Investigadores de los Centros para el Control y la Prevención de Enfermedades (CDC) de EE.UU. descubrieron que un virus mortal llamado Chapare, que lleva el mismo nombre de la provincia boliviana donde se registró por primera vez en 2004, se puede contagiar de persona a persona, algo que eleva la preocupación ante posibles futuros brotes.
Hasta ahora, los expertos solo sabían que este virus se transmite por el contacto con la orina o excrementos de ratas. Sin embargo, se investigó un pequeño brote ocasionado en el 2019, cuando se registraron cinco infecciones y tres fallecimientos, reflejando el elevado índice de letalidad.
Para la indagación, revelada ante la Sociedad Americana de Medicina e Higiene Tropical (ASTMH), los especialistas estudiaron la línea de transmisión: un agricultor de arroz de 65 años posiblemente contrajo la enfermedad al estar en contacto con roedores, y luego contagió a los médicos que lo atendieron. En efecto, los entendidos determinaron que un doctor de 25 años que cuidó al paciente se enfermó a los nueve días, y lo mismo le ocurrió al gastroenterólogo que le hizo una endoscopia a su colega infectado. Como resultado, los tres fallecieron.
Asimismo, un técnico de ambulancia que le habría hecho una reanimación cardiopulmonar al paciente inicial, sumado a otro agricultor, también se contagiaron, pero sobrevivieron. Por otro lado, se detectó carga viral en el semen de un sobreviviente 168 días después del contagio, lo que abre la posibilidad de la transmisión sexual, aunque todavía deben avanzar los estudios.
Síntomas
Por lo pronto, no existe un tratamiento específico para las afecciones que genera el Chapare, más allá de los cuidados intensivos. Al igual que el Ébola, este arenavirus puede causar fiebre, dolor de cabeza, malestar en los abdominales, sarpullido, insuficiencia orgánica y hemorragias, potencialmente mortales.
En cuanto a los riesgos de propagarse una enfermedad en gran escala, en la actualidad se sabe que los roedores que transmiten el arenavirus son ratas de arroz pigmea, que habitan en Bolivia y otros países vecinos. Esta clase de virus son vulnerables al calor y los desinfectantes, por lo que se cree que una propagación global es poco probable.
Igualmente, temen que el Chapare haya estado circulando durante los últimos años en el país andino, y que los contagios hayan sido diagnosticados de forma errónea como casos de dengue, que solo se transmite por un tipo de mosquito, y no entre las personas.